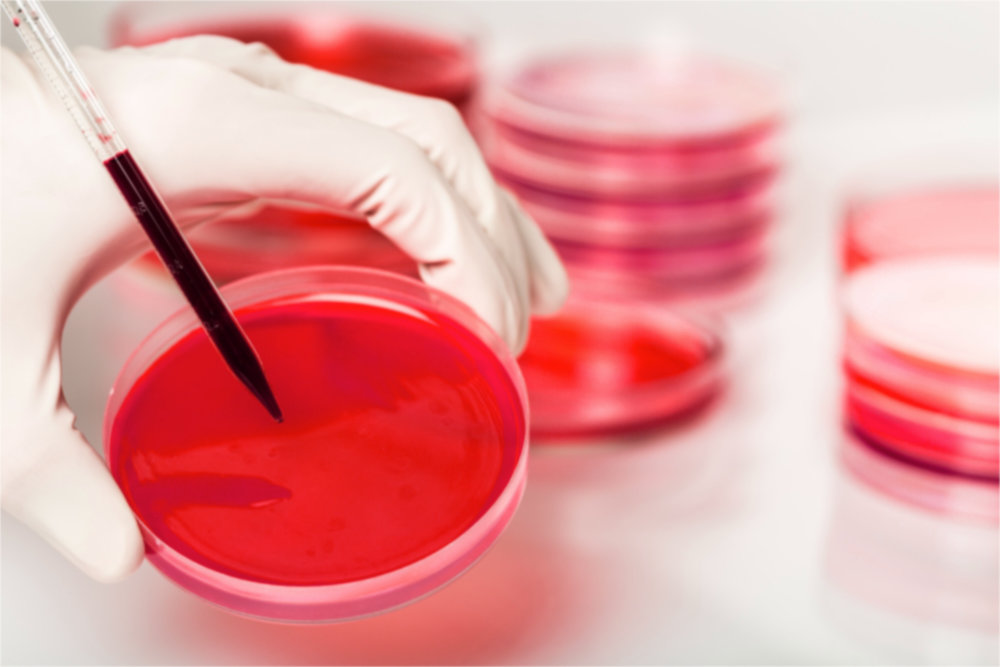

Studie zeigt, dass das Blut von Veganern Krebszellen 8-mal besser abtötet als das Blut von Omnivoren
Eine interessante Untersuchung mit dem Blut von Omnivoren, Vegetariern und Veganern zeigt, welches Blut das Wachstum von Krebszellen im Labor am besten hemmt: Das Blut von Veganern hemmt das Krebswachstum etwa 8mal stärker als das Blut eines Omnivoren.
Diese Studie erfolgte unter der Leitung von Prof. Dr. Dean Ornish, der bereits in einer anderen Studie nachgewiesen hat, dass die koronare Herzkrankheit (weltweit Todesursache Nr. 1 in den Industrieländern) mit einer veganen Ernährung vollständig gestoppt und sogar rückgängig gemacht werden kann.
Ein anderes ähnliches, aber kurzfristiges Experiment hat eine dramatische Stärkung der Krebsabwehr gegen Brustkrebszellen nach nur 14 Tagen des pflanzenbasierten Essens und leichten Bewegungsübungen gezeigt.
Nur zwei Wochen, Früchte, grünes Blattgemüse, und Hülsenfrüchte als Hauptnahrung haben dazu geführt, dass sich Krebswachstum bedeutsam verlangsamt hatte.
Vegetarisch-vegan lebende Menschen haben tatsächlich, gegenüber der Allgemeinbevölkerung, ein deutlich geringeres Risiko an Krebs zu erkranken und zu sterben. Vorteile ergeben sich insbesondere bei Dickdarm- und Lungenkrebs, in geringerem Maße auch bei Magen-, Brust- und Prostatakrebs. Besonders bei männlichen Veganern ist die Krebshäufigkeit und -sterblichkeit geringer als bei nicht vegan lebenden Männern.
Das Krebsrisiko kann durch eine vegetarisch-vegane Ernährung nicht ausgeschlossen, aber ganz entscheidend reduziert werden. Prof. Dr. Claus Leitzmann, ehemaliger Leiter des Instituts für Ernährungswissenschaft in Gießen und Träger des Zabelpreises für Krebsprävention.
Ernährung und Krebsentstehung
Da Tumorerkrankungen über einen langen Zeitraum entstehen und zahlreiche individuelle Faktoren zu berücksichtigen sind, sind direkte Rückschlüsse auf die Ernährung als Krankheitsursache schwierig. Dennoch gibt es zahlreiche Hinweise für die Bedeutung der Ernährung bei der Krebsentstehung, auch wenn die genauen biochemischen Abläufe noch weitgehend unbekannt sind. Die Lebensmittelauswahl bestimmt, in welchem Maße, die in der Nahrung enthaltenen Krebs fördernden bzw. hemmenden Substanzen aufgenommen werden.

Obst und Gemüse sind Krebshemmer
Aufgrund ihres höheren Obst- und Gemüseverzehrs sind vegetarisch-vegan lebende Menschen gut mit den genannten Stoffen versorgt, wodurch das Krebsrisiko besonders im Alter sinkt.
Vegetarisch-vegan lebende Menschen haben aufgrund ihres überdurchschnittlichen Verzehrs von Obst, Gemüse, Getreide und Hülsenfrüchten meist eine hohe Zufuhr an sekundären Pflanzenstoffen. Dementsprechend weisen Vegetarier und vor allem Veganer beispielsweise höhere Blutkonzentrationen an Carotinoiden und Phytoöstrogenen auf als Nichtvegetarier.
Als Krebshemmer gelten, die in Obst und Gemüse reichlich vorhandenen, Antioxidantien. „Das sind Stoffe, die die Zellen vor Schäden schützen und ihre Entartung verhindern. Und als Veganer nimmt man sie in besonders hohem Maße auf“, erklärt Zehra Karadeniz vom Verband der Oecotrophologen. Das zeigte sich auch in der Deutschen Vegan Studie von 2005, die die Vorteile veganer Kost untersuchte.
Das größte Forschungsprogramm über die biochemischen Wirkungen krebshemmender Lebensmittel wurde vom kanadischen Biochemiker Prof. Dr. med. Richard Beliveau durchgeführt. Prof. Beliveau hat die Ergebnisse seiner Forschungsarbeit zusammen mit Dr. D. Gingras in einem sehr gut lesbaren Ratgeber unter dem Titel “Krebszellen mögen keine Himbeeren” zusammengefasst.
Viele Nahrungsmittel, enthalten Wirkstoffe, die jenen ähneln, die in Medikamenten enthalten sind. “Die Integration in den alltäglichen Speiseplan schafft Bedingungen, die die Weiterentwicklung von tumoralen Mikroherden verhindern, die spontan in Laufe unseres Lebens entstehen. Krebsprävention durch Ernährung ist also gleichbedeutend mit einer nichttoxischen Chemotherapie,” kann man im Ratgeber der kanadischen Autoren lesen.
In diesem Buch wird absolut überzeugend erklärt, mit welchen trickreichen Mechanismen, Krebszellen durch die Aufnahme von sekundären Pflanzenstoffen am Wachstum gehindert werden. Auch in einem gesunden Körper bilden sich immer wieder Mikrotumore, die bei guter Gesundheit erfolgreich bekämpft werden. Erst wenn zu viele krebserregende Wirkstoffe im Körper sind, und der Körper nicht genügend Abwehrkraft hat, kommt es zu einem Wachstum der Krebszellen. Das verdeutlicht, wie sinnvoll es ist, sich jeden Tag gesund zu ernähren.
Der Verzehr von Obst und Gemüse trägt wahrscheinlich zur Senkung des Risikos von Tumoren des Verdauungstrakts (Mund, Rachen, Kehlkopf, Speiseröhre, Magen, Dickdarm) bei. Obst senkt außerdem das Risiko für Lungenkrebs. Die günstige Wirkung eines hohen Obst- und Gemüseverzehrs konnte bisher nicht eindeutig einzelnen Substanzen zugeordnet werden. Vielmehr ist davon auszugehen, dass die vor Krebs schützende Wirkung auf einem komplexen Zusammenwirken verschiedener Inhaltsstoffe, wie Vitamin C und E, sekundäre Pflanzenstoffe, lösliche Ballaststoffe und Folat, beruht.
Ausserdem ist das meiste Obst und Gemüse basenbildend, auch Zitrusfrüchte beispielsweise. Pflanzliche Öle sind neutral. Die meisten Nüsse, Hülsenfrüchte und Getreide sind moderate Säurebildner, überschaubare Mengen davon gehören aber auf jeden Fall zu einer ausgewogenen Ernährung dazu. Als stark säurebildend gelten Fleisch, Fisch, Eier, Käse, Zucker, Weißmehl, Kaffee und Alkohol.
Krebs entsteht in einem sauren Milieu
So wurde beispielsweise festgestellt, dass Krebs am häufigsten bei Menschen auftritt, deren Körper einen sehr sauren pH-Wert aufweist.
Die Tatsache, dass bei 40% der Bevölkerung, aufgrund ihrer derzeitigen gesundheitlichen Situation, eine Krebserkrankung als Folgeerkrankung zu erwarten ist, weist auf die heute weit verbreitete Übersäuerung der Menschen, und der dazugehörenden falschen Ernährungsweise hin.
Ballaststoffreiche Lebensmittel
Ballaststoffreiche Lebensmittel, tragen zur Senkung des Dickdarmkrebsrisikos bei. Möglicherweise beugen sie auch Magen- und Mastdarmkrebs vor.
Schauen wir uns als erstes die Waffen an, die man dem Körper zur Krebsbekämpfung bereitstellen kann
Früher hat man besonders die positiven Aspekte der Vitamine, Mineralstoffe und Ballaststoffe in pflanzlicher Nahrung hervorgehoben. Jetzt weiß man aber auch welche wichtige Rolle sekundäre Pflanzenstoffe spielen. Das sind Moleküle, die es den Pflanzen ermöglichen, sich vor Feinden, d. h. Infektionen, Bakterien, Pilzen und Insekten zu schützen.
Und das ist das interessante daran: Die Schutzwirkung der sekundären Pflanzenstoffe nutzt auch dem Menschen bei der Abwehr gegen Krebs.
Ein äußert starker Mechanismus der sekundären Pflanzenstoffe ist die Anti-Angiogenese. Anti-Angiogenese bedeutet Hemmung der Bildung von Blutgefäßen. Wenn ein Tumor entsteht, hat er zunächst noch keine eigenen Blutgefäße. Sein Wachstum ist deshalb stark eingeschränkt. Ohne eigene Blutgefäße wird er nicht größer als 1 bis 2 mm und kann keine Metastasen bilden. Seit langem ist bekannt, dass es bei Krebserkrankungen zu einer Gefäßneubildung kommt, die man dann „Tumor-Angiogenese“ nennt. Denn Tumore bestehen aus Zellen, die genau wie gesunde Körperzellen Sauerstoff und Nährstoffe brauchen. Weil sich Krebszellen häufig teilen, ist ihr Bedarf sogar besonders hoch – und deshalb benötigen Tumore eine eigene Blutversorgung.
Der Verzehr von vielen sekundären Pflanzenstoffen hemmt die Bildung dieser feinsten Blutgefäße, was unweigerlich zum Absterben der Krebszellen führt!! Aber es gibt noch weitere tolle Waffen: Das Essen von Gemüse aus der Kreuzblütler Familie sowie aus der Knoblauchfamilie helfen dem Körper dabei, krebsauslösende Substanzen, die täglich in unseren Körper gelangen, auszuschleusen und somit krebsauslösende Mutationen der DNS zu verhindern. Des weiteren deuten verschiedene Studien auf eine Abnahme des allgemeinen Krebsrisikos durch den Verzehr von Lycopin-haltigen Nahrungsmitteln hin. Dieser sekundäre Pflanzenstoff findet sich in allen roten Gemüsesorten.

Krebszellen mögen tierisches Eiweiß
Es gibt diverse Studien, die die Entstehung von Krebs mit dem Konsum von tierischem Eiweiß in Verbindung bringen. An erster Stelle ist das vielzitierte Buch „The China Study“ zu nennen. Darin interpretiert Prof. Colin Campbell eine groß angelegte Studie aus den 80-er Jahren, die von der Cornell University, der University of Oxford und der chinesischen Regierung unterstützt wurde.
Wenn Fleisch (alle Sorten, einschl. Rind, Schwein, Geflügel, Fisch etc.) zubereitet wird, dann bilden sich aus den tierischen Eiweißen sog. heterozyklische Amine. Heterozyklische Amine sind krebserregende Substanzen, die zur Entstehung bösartiger Tumore beitragen können. – Prof. Colin Campbell
Zum anderen werden beim Essen von tierischem Eiweiß die Enzyme der Bauchspeicheldrüse (Trypsin, Chymotrypsin) „verbraucht“. Es stehen weniger dieser Enzyme dann noch zur Verfügung, um die Eiweiß-Hüllen (Proteinhüllen) von vagabundierenden Krebszellen aufzulösen. Diese Enzyme können Krebs zwar nicht heilen, aber das Tumorwachstum und die Metastasenbildung hemmen, wie eine Studie aus den 90-er Jahren ergab.
Der Verzehr von Fleisch erhöht mit steigender Menge das Risiko für Dickdarm- und Mastdarmkrebs. Tumoren der Speiseröhre, Lunge und Gebärmutterschleimhaut treten wahrscheinlich ebenfalls häufiger auf. Der Konsum von haltbar gemachten Fleischprodukten (geräuchert, gepökelt, gesalzen, mit chemischen Konservierungsstoffen versetzt) erhöht das Dickdarmkrebsrisiko und vermutlich auch das Risiko für Speiseröhren-, Lungen-, Magen- und Prostatakrebs. Pro 100 g rotem Fleisch pro Tag steigt das rechnerische Krebsrisiko, vor allem für Dickdarmkrebs, um etwa 20 %, pro 100 g Fleischprodukten pro Tag zwischen 30 und 200 %.
Verantwortlich für das erhöhte Krebsrisiko durch Fleischverzehr sind Stoffe, die bei der Zubereitung entstehen (heterozyklische aromatische Amine, polyzyklische aromatische Kohlenwasserstoffe) sowie im Fleisch enthalten sind (Stickstoffverbindungen, Eisen). Diese Substanzen können die DNA schädigen oder fördern krebserregende Zellveränderungen.
Krebszellen entstehen in jedem Körper
Jeden Tag entstehen in unserem Körper tausende entartete Zellen. Normalerweise vernichten enzymgesteuerte Antikörper und aktive Immunzellen diese Zellenbildung. „Ist das Abwehrsystem aber geschwächt, werden die entarteten Zellen nicht so schnell erkannt und zerstört. Das Risiko wird größer, dass sich aus einem ungefährlichen Zellhaufen ein Tumor entwickelt. Das heißt, die Immunabwehr könnte durch Verdauen von tierischen Eiweißen, unter Umständen nicht genügend dieser Enzyme für den Angriff auf die Krebszellen durch die Immunabwehr haben.
Des weiteren wurde laut Campbell in Labortests bewiesen, dass Kasein, (87% des Proteins, das in Milch und Milchprodukten enthalten ist) das Wachstum von Krebszellen stimuliert und fördert.
Lebensstil und Krebsentstehung
Vegetarisch-vegan lebende Menschen unterscheiden sich nicht nur in ihrer Ernährungsweise, sondern auch in verschiedenen Lebensstilfaktoren von der Allgemeinbevölkerung.
Übergewicht ist ein bedeutender Risikofaktor für Tumorerkrankungen. Da vegetarisch-vegan lebende Menschen meist ein normales bis niedriges Körpergewicht aufweisen, verringert sich ihr Krebsrisiko.
Das Risiko für Brustkrebs erhöht sich, wenn Frauen jahrzehntelang hohen Östrogenspiegeln ausgesetzt sind. Vegetarierinnen weisen nach der Menopause einen niedrigen Östrogenspiegel auf, was teilweise auf die geringere Fettzufuhr durch die Nahrung zurückzuführen ist. Eine hohe Fettzufuhr fördert die Bildung körpereigener Östrogene. Zusätzlich schützt eine mäßige Fettzufuhr vor Übergewicht und damit vor einem unabhängigen Risikofaktor für Brustkrebs und andere Krebserkrankungen.
Alkoholkonsum erhöht das Risiko für Tumorerkrankungen der Brust und des Verdauungstrakts (außer Magen). Eine Mindestmenge, unterhalb der kein Anstieg an alkoholbedingten Krebserkrankungen zu verzeichnen ist, kann aufgrund der wissenschaftlichen Datenlage nicht festgelegt werden.
Nährstoffstatus regelmäßig prüfen
Voraussetzung für ein gesundes, veganes Leben ist, nicht einfach drauflos zu essen. Wenn man vegan lebt, aber nur Junkfood zu sich nimmt, ist das natürlich nicht gesund. Man muss sich schon ausgewogen ernähren.
Fazit
- Vegetarisch-vegan lebende Menschen haben ein niedrigeres Krebsrisiko als die Allgemeinbevölkerung.
- Ein hoher Verzehr pflanzlicher Lebensmittel senkt das Risiko, an Krebs zu erkranken.
- Ein niedriges Körpergewicht, eine geringe Gesamtfettaufnahme, das Meiden von Tabakrauch und ein verringerter Alkoholkonsum tragen ebenfalls zur Krebsvorsorge bei.
Empfehlung zum Thema:
Krebszellen mögen keine Himbeeren: Nahrungsmittel gegen Krebs. Das Immunsystem stärken und gezielt vorbeugen
Studie:
www.ornish.com/wp-content/uploads/Intensive_Lifestyle_Changes_and_Prostate_Cancer.pdf
Zeitungsartikel:
www.ecorazzi.com/2016/05/17/study-finds-vegan-blood-kills-cancer-cells-better/










Hallo, ja auch ich bin ein grosser Fan von Euren Berichten. Immer sehr sehr Interesseant und Informativ.
Ganz herzlichen Dank dafür.
Ich finde es sehr wertvoll das solche Informationen dem Verbraucher und Konsumenten zugänglich gemacht werden! Vielen Dank dafür! Die Welt hat sich geändert und wird sich weiterhin ändern! Die Naturgesetze aber bleiben bestehen! Und solange der Mensch im Einklang mit den Naturgesetzen lebt, ist er gut geschützt und behütet! Dies gilt auch im Bereich der Ernährung!
Alles Liebe
Stefan Transfeld